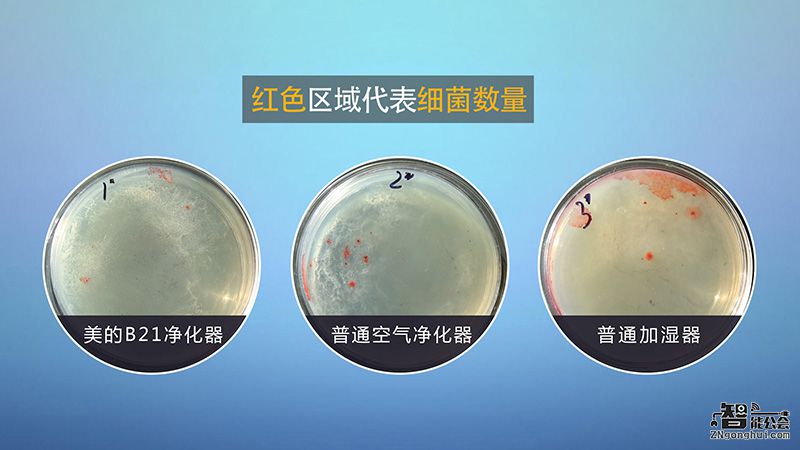
探究：加湿器、空气净化器到底能不能合二为一？ 智能公会

每年的秋冬季节,都是雾霾来袭最为频繁的时候,虽然社会日益进步,但是对环境的破坏却起到了退化作用,空气污染、干燥、混浊,室内空气环境所引起的疾病也越来越多,而加湿器、空气净化器则成了市场的香馍馍,销售异常火爆。

对于大部分家庭来说加湿器+空气净化器已经成为秋冬季节标配,但是两台电器占用空间不说,而且实际效果也并不理想。有网友表示,把空气净化器和加湿器靠的太近,净化器的警报就会响起,空气污染指数也会一路飙升。


这是因为加湿器通过超声波打散内部的水分子,然后将水分子扩散到空气中,而空气净化器很容易将其理解成颗粒物质,从而发出警报。另外,如果在加湿器中加入的不是纯净水,而是自来水的话,由于自来水含有较多矿物质、杂质,水中的氯分子和微生物可能会随加湿器喷出的水雾吹入空气中,形成污染源。

为迎合消费需求,市场上带有加湿功能的空气净化器也屡见不鲜,这样的产品不就解决了以上问题了吗!“花一份钱买两个功能"的好处,使其受到了部分消费者的欢迎。但业内人士表示,空气净化器的加湿功能不但会降低滤网寿命,甚至易造成二次污染。


消费者孔女士表示,她家里有一个五岁的小孩,平时身体很好,但是一到冬季天气不好的时候,咳嗽的就很严重,开启家里的空气净化器(带有加湿功能)刚开始有所好转,但是过了一段时间,不仅咳嗽没有好,还引起了嗓子发炎等症状,去医院检查后才知道是病毒感染。


据医学院专家介绍,冬天室内空气流动性差,一些细菌、霉菌在适宜的条件下,会迅速地生长繁殖,加湿器如果不定期清理,这些有害微生物就会随汽雾进入空气,再进入人的呼吸道,引起“加湿器肺炎”,损害人的健康抵抗力相对较弱的老人、儿童尤其应注意。


目前市场上带有加湿功能的空气净化器,仅仅就是把两个产品简单的结合到一起,产品的弊端没有得到合理的解决,所以让空气净化器吹出干净而且湿度合适的风,才是消费者真正的需求。智能公会了解到,美的B21空气净化为了解决这一问题,推出了带有抗菌循环保护的加湿功能,先杀菌再加湿。那么它的实际效果如何呢?我们做个实验来检测一下:






工作人员分别从加湿器、普通空气净化器和美的空气净化器三种产品中提取细菌样本,分别放入三个细菌培养皿,让后放到恒温恒湿箱中培养。

三天以后,我们取出三个培养皿,发现经过培养后,从加湿器取样的培养皿细菌菌落最为明显,普通加湿器次之,美的空气净化器几乎没有太大变化。

实验表明,普通加湿器需要经常清洁,否则水箱细菌超标。而普通净化器虽然能过滤pm2.5但是吹出的风细菌超标,美的净化器空气过滤合格 细菌检测合格!

是什么原因能让美的净化器有如此好的净化效果呢?原来B21采用了抗菌加湿滤网和抗菌ABS材质的水槽和3L大水箱,加上DUV深紫外线杀菌灯,四个方面全方面抗菌杀菌,这样就能杜绝加湿器细菌滋生的诟病了!

尽管空气净化器市场上鱼龙混杂,价格高低不等,但是只要消费者从正规渠道购买的大品牌产品,基本就不会遇到伪劣产品,当然,至于您想要选什么类型的,那肯定因人而异,但是对于中国大部分的地区,冬季普遍干燥而且空气污染严重,所以一台可以杀菌的加湿型空气净化器还是非常值得推荐的!

